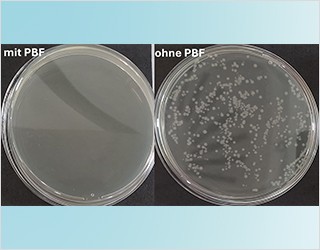

Das Fraunhofer-Institut für Elektronenstrahl- und Plasmatechnik FEP hat die behördliche Genehmigung für die Aufnahme von Tätigkeiten mit biologischer Schutzstufe 2 erhalten. Damit eröffnet der Laborkomplex neue Forschungs- und Testmöglichkeiten für Industrie- und Projektpartner. Diese Zulassung markiert einen wichtigen Meilenstein in der Entwicklung der Biomedizinischen Laboreinheit am Institut.
mehr Info Fraunhofer-Institut für Elektronenstrahl-
Fraunhofer-Institut für Elektronenstrahl-